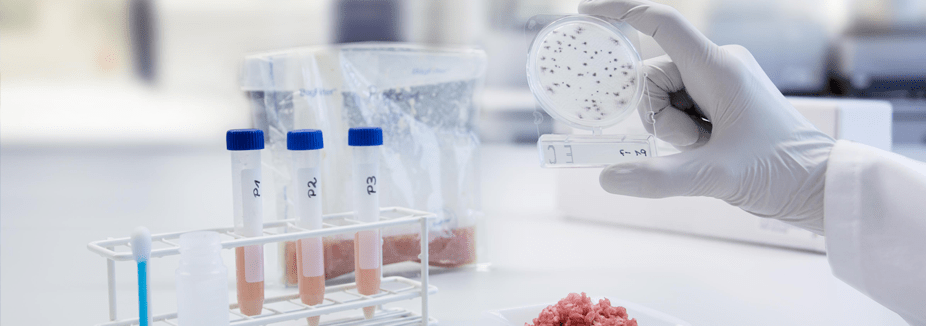

Validación y verificación de métodos microbiológicos en alimentos
| El laboratorio debe utilizar métodos de ensayo apropiados con el fin de satisfacer las necesidades específicas a su campo de aplicación. De manera general y con fines reglamentarios, se utilizan métodos estándar normalizados (ej. normas ISO, otros) o métodos alternativos validados (ISO 16140-2), teniendo en cuenta las etapas de verificación de la implementación y verificación de “artículos” alimentarios (ISO 16140-3). En ambos casos, el laboratorio debe verificar que puede llevar a cabo apropiadamente los métodos antes de su utilización. El procedimiento detallado a seguir varía según la naturaleza del método; cualitativo, semicuantitativo o cuantitativo. Por otro lado, el laboratorio puede emplear métodos de referencia no validados teniendo en cuenta únicamente la etapa de verificación de “artículos” alimentarios. En la verificación de los métodos de ensayo también se tendrá en cuenta la verificación de las etapas de confirmación y tipificación según la naturaleza del método. Alcance. Microbiología alimentos. Objetivo. Dotar a los asistentes de los fundamentos, diseño, técnicas e interpretación de los resultados de la verificación de métodos de referencia y alternativos validados, métodos de referencia no validados y, las etapas de confirmación y tipificación, para su implementación en las actividades de ensayo a realizar en el laboratorio del usuario. Dirigido a: Responsables y personal técnico de laboratorios agroalimentarios y sanitarios y, todo personal relacionado con el área de inocuidad alimentaria. Profesorado: Profesional cualificado con experiencia en procesos de implantación y evaluación de la norma en laboratorios. Diploma: Certificado de asistencia |
| Modalidad: Online 💻🌍 | Precio 💰 | Fecha impartición 📅 / Horario ⏰ |
|---|---|---|
| España Latam | 135 € (impuestos incluidos) 135 € al cambio USD($) | 👉 Ver programación de cursos |
Contenido curso
📒 PROGRAMA DE CURSO
- Introducción a la validación y verificación de métodos de ensayo
- Reglamentación, nomas y documentos de referencia
- Requerimientos ISO 170125:2017 y otras normas de compertencia de laboratorios.
- Categorías de alimentos (rangos de aplicación)
- Patógenos asociados (Levaduras, mohos, bacterias, virus)
- Conceptos estadísticos
- Naturaleza y distribución microbiana
- Parámetros de desempeño
- Selección de métodos de ensayo
- Métodos de ensayo (cuantitativos, cualitativos, confirmación)
- Técnicas (filtración, siembra directa, dilución/elución, NMP, inmunoensayos, qPCR)
- Microorganismos de referencia. Estandarización y titulación
- Criterios generales de validación y verificación
- Verificación de métodos cualitativos (ISO 16140-3)
- Protocolo técnico de verificación.
- Determinación de eLOD50.
- Verificación de métodos cuantitativos (ISO 16140-3)
- Protocolo de verificación
- Determinación SIR y eBIAS.
- Verificación de métodos de confirmación y serotipado. (ISO 16140-3)
- Protocolo de verificación
- Verificación de métodos de referencia no validados. (ISO 16140-3)
- Protocolo de verificación
- Incertidumbre de ensayo (métodos cuantitativos) (ISO 19036)
- Expresión de resultados
- Aseguramiento de la calidad
- Casos prácticos
| 📌Reserva de plaza A la recepción de tú solicitud de inscripción, se te notificará la reserva de plaza, fecha de realización del curso, plazo y forma de pago. |




Servicios complementarios: Consultoría y auditoría interna de SGC. Asesoramiento técnico (in situ y/o bonos horas on-line). Elaboración documental (PNTs, ITs, hojas de cálculo,….).
